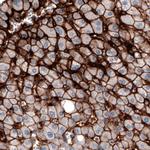
OATP8 Antibody in Immunohistochemistry (Paraffin) (IHC (P))

Search
Invitrogen
OATP8 Monoclonal Antibody (CL3771)
{{$productOrderCtrl.translations['antibody.pdp.commerceCard.promotion.promotions']}}
{{$productOrderCtrl.translations['antibody.pdp.commerceCard.promotion.viewpromo']}}
{{$productOrderCtrl.translations['antibody.pdp.commerceCard.promotion.promocode']}}: {{promo.promoCode}} {{promo.promoTitle}} {{promo.promoDescription}}. {{$productOrderCtrl.translations['antibody.pdp.commerceCard.promotion.learnmore']}}

Please note: We are reviewing Western blot images included in the antibody testing data in our catalog, including those provided by third parties. Unless expressly labeled or annotated as “raw-unedited”, Western blot images included in the antibody testing data in our catalog may have been edited, optimized or otherwise adjusted for presentation.
产品信息
MA5-35016
种属反应
宿主/亚型
分类
类型
克隆号
偶联物
形式
浓度
规格
纯化类型
保存液
内含物
保存条件
运输条件
RRID
产品详细信息
Immunogen sequence: QGKDTKASDN ERKVMDEANL EFLNNGEHFV PSAGTDSKTC NLDMQDNAAA
Highest antigen sequence indentity to the following orthologs: Mouse - 33%, Rat - 32%.
靶标信息
SLCO1B3, also known as OATP8 or OATP1B3, is a member of Organic Anion Transporting Polypeptides (OATPs) which are sodium-independent organic anion transporters mediating the uptake of a wide range of structurally diverse endogenous and exogenous compounds including bile acids, hormone conjugates, peptides, toxins, as well as a multitude of therapeutic drugs. SLCO1B3 is specifically expressed in liver under normal condition, while its expression has also been observed in cancer tissues like colon, prostate and pancreas. The molecular mass of SLCO1B3 is highly dependent on the glycosylation modification (deglycosylated form of 65 kDa, fully-glycosylated form of 120 kDa).
仅用于科研。不用于诊断过程。未经明确授权不得转售。
篇参考文献 (0)
生物信息学
蛋白别名: Liver-specific organic anion transporter 2; LST-2; OATP-8; OATP1B3; Organic anion transporter 8; Organic anion-transporting polypeptide 8; Solute carrier family 21 member 8; Solute carrier organic anion transporter family member 1B3
基因别名: LST2; OATP1B3; OATP8; SLC21A8; SLCO1B3
Entrez Gene ID: (Human) 28234




